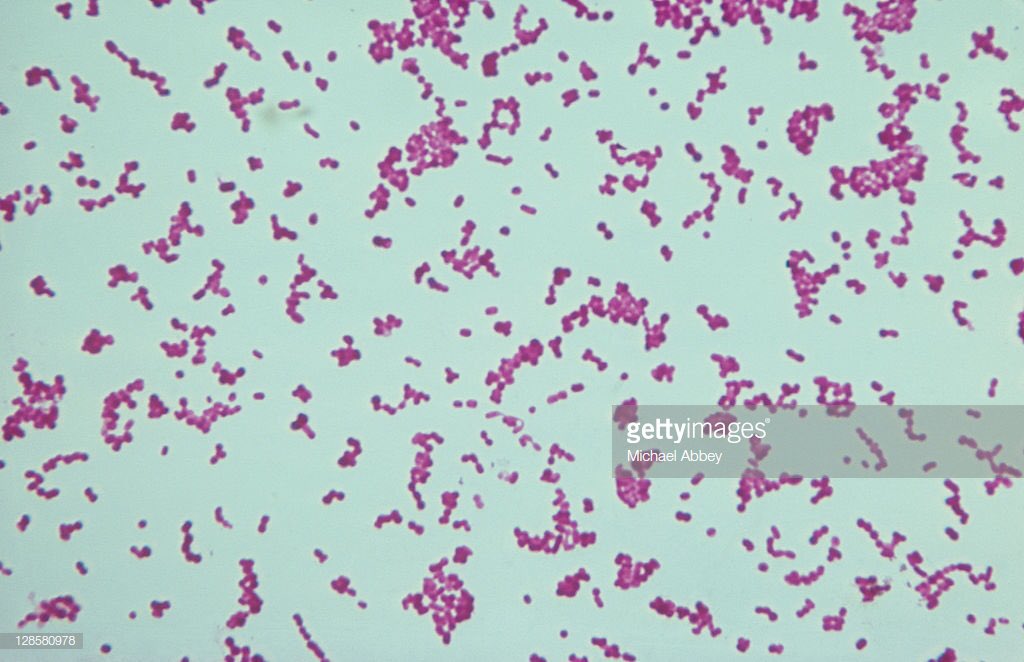

Грамотрицательные кокки возбудители
Море море дэнс песня
Компания торговый порт
Глобус фурманов построят
Miracle moist
Учет целевого финансирования проводки
Lp lost on you swanky
Некрасовский педагогический колледж приказ о зачислении 2025
Речная гроза мелкой рыбешки 5
Лайфхаки отопления
Мгу оы
Заброшки обнинск
Автодок по вину
Богатырская калининград
Грамотрицательные кокки возбудители 113 фотографий